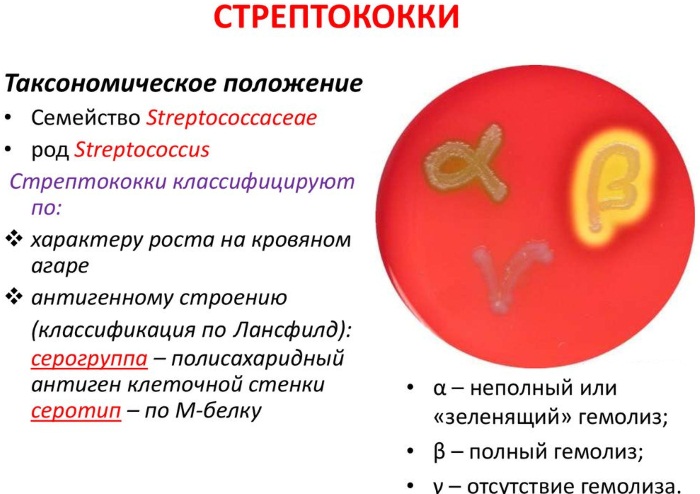
Микробы под микроскопом. Фото на руках, во рту, под ногтями. Какие бывают, как выглядят, презентация для детей

Микробы окружают нас повсюду. Хотя их не видно невооруженным глазом, они важны для нашей жизни. В этой статье мы познакомим детей с миром микробов, обитающих на руках, во рту и под ногтями. Рассмотрим виды микробов, их внешний вид под микроскопом и роль в экосистеме человека. Эта информация поможет детям понять, что микробы могут быть как полезными, так и опасными, что способствует осознанному отношению к личной гигиене и здоровью.
Общие сведения о микробах
Эти крошечные организмы получили свое название от сокращения термина «микроскопический объект». Впервые оно было предложено в 1878 году французскими учеными Эми́лем Литтре́ и Шарлем Седийо.
Миллиарды таких микробов обитают в воздухе, на поверхности земли и в водоемах, а также являются частью организмов людей, животных и растений. Первым, кто увидел микробы, стал голландский оптик Антони Левенгук, который, рассматривая каплю обычной воды через увеличительное стекло, обнаружил их.
Микробы считаются самыми древними обитателями нашей планеты, их история насчитывает более 3,5 миллиардов лет. В течение первого миллиарда лет на Земле они были единственными живыми существами. В человеческом организме соотношение микробов и собственных клеток составляет 50 на 50. Большинство микроорганизмов оказывают положительное влияние на здоровье.
Существует две основные группы микробов: прокариоты, не имеющие ядра, и эукариоты, в клетках которых присутствует ядро.
Широкое распространение микробов и их огромное количество делают их ключевыми для поддержания баланса в биосфере нашей планеты.
Разнообразие форм микробов:
| Микробы | Форма |
| Стафилококки и стрептококки | Круглые кокки |
| Спирохеты | Спиралевидные организмы |
| Бациллы | Палочковидные |
| Бифидобактерии | Обитают в кисломолочных продуктах и напоминают двузубую пилу. |
Существуют также многогранные микробы, имеющие форму звезд, треугольников и других фигур. Некоторые из них неподвижны, но большинство обладает жгутиками и может передвигаться.
Классификация микробов:
- бактерии;
- простейшие одноклеточные организмы, такие как амебы;
- микроскопические грибы.
Врачи подчеркивают, насколько важно понимать микробы, которые нас окружают. На руках, во рту и под ногтями живут различные микроорганизмы, и их изучение может быть увлекательным и познавательным для детей. Например, под микроскопом можно увидеть бактерии, такие как стафилококки и стрептококки, которые выглядят как маленькие шарики или цепочки. Во рту обитают как полезные, так и потенциально опасные микробы, способные вызывать заболевания. Важно объяснить детям, что не все микробы вредны; многие из них способствуют поддержанию здоровья. Презентация о микробах может стать отличным способом заинтересовать детей наукой и научить их основам гигиены. Врачи рекомендуют проводить такие занятия, чтобы формировать у детей правильное отношение к микробам и заботу о собственном здоровье.
Эксперты в области микробиологии подчеркивают важность изучения микробов, которые окружают нас повсюду. На руках, во рту и под ногтями можно обнаружить множество различных микроорганизмов, каждый из которых имеет свои уникальные характеристики. Например, на коже человека часто встречаются стафилококки, которые могут быть как безвредными, так и потенциально опасными. Во рту обитают стрептококки и другие бактерии, играющие ключевую роль в процессе пищеварения, но также способные вызывать кариес. Под ногтями можно найти грибки, которые могут вызывать инфекции. Презентация для детей о микробах должна быть яркой и наглядной, чтобы заинтересовать юных исследователей. Использование микроскопа позволяет увидеть эти крошечные организмы в деталях, что делает изучение микробов увлекательным и познавательным процессом.

Бактерии во рту
Полость рта – самая населенная бактериями область организма. Это связано с тем, что в этом месте подходящие условия для развития микробов: здесь тепло, постоянная влажность, а кислотность и насыщенность кислородом – самые наилучшие для микроорганизмов. Много во рту и всевозможных питательных веществ.
Постоянно здесь живет около 30 видов бактерий. Интересно, что видовой состав бактерий у человека не меняется, а количество каждого конкретного вида микробов на протяжении жизни может измениться. Основу микрофлоры составляют бактерии, среди которых 90% могут жить без кислорода.
Больше всего бактерий находится на спинке языка. Здесь образуется мельчайший налет, в 1 г которого можно найти почти 300 миллиардов бактерий. Второе любимое место жительства для большинства бактерий – поверхность зубов. Микробы под микроскопом (фото стрептококков, вызывающих ангину) позволяют увидеть их строение.
Те микробы, которые постоянно находятся в полости рта, взывают пародонтит и кариес. На сегодня кариесом болеют 95% людей.
Во рту человека постоянно находят такие бактерии:
- Вейлонелла алкасенсес. Это микроб, приводящий к развитию инфекционных заболеваний.
- Грибы Кандида. Более 100 видов таких грибов могут быть болезнетворными и нормальными, не вызывающими болезней.
- Бактерии Лептотрикс, очень похожие на изогнутые палочки с острыми либо круглыми краями. Найти их можно в пришеечной зоне зубов. Эти бактерии формируют зубной камень и вызывают неприятный запах изо рта.
- Коринебактерии, ведущие к развитию гнойных воспалений при заболеваниях десен или зубов.
- Лактобактерии казеи. Эти микроорганизмы вырабатывают жирные кислоты. Именно они создают неприятный запах изо рта.
- Трепонема зубная. Эта бактерия принимает участие в разрушении десен и напрямую зависит от гигиены полости рта.
- Солобактерии Мура выступают причиной тяжелого гнилостного запаха в ротовой полости: они вырабатывают сероводород, который очень быстро испаряется и попадает в воздух выдоха.
- Стрептококки, образующие цепочки шаровидных анаэробных бактерий.
- Стафилококки, способные жить в воздухе и вызывать гнойные заражения. Они могут привести к воспалению легких, к тяжелейшей пневмонии и к общему сепсису.
| Место обитания | Тип микроба | Как выглядит (для детей) |
|---|---|---|
| Руки | Бактерии (стафилококки, стрептококки) | Маленькие шарики или цепочки из шариков, иногда похожи на виноградные грозди. |
| Грибки (дрожжи, плесень) | Пушистые ниточки или маленькие пятнышки, как будто кто-то рассыпал муку. | |
| Вирусы (грипп, ОРВИ) | Очень-очень маленькие точки, которые можно увидеть только в самый сильный микроскоп. | |
| Рот | Бактерии (стрептококки, лактобактерии) | Шарики, палочки, спиральки – очень много разных форм, как будто зоопарк из микробов! |
| Грибки (кандида) | Овальные клеточки, иногда похожие на маленькие почки. | |
| Простейшие (амебы) | Маленькие бесформенные комочки, которые медленно ползают. | |
| Под ногтями | Бактерии (стафилококки, кишечная палочка) | Те же шарики и палочки, что и на руках, но их там очень много, потому что им тепло и темно. |
| Грибки (дерматофиты) | Длинные тонкие ниточки, которые могут расти и образовывать целые сети. | |
| Яйца паразитов (острицы) | Очень маленькие овальные или круглые точки, которые почти не видно. |
Интересные факты
Вот несколько интересных фактов о микробах, которые можно использовать в презентации для детей:
-
Микробы повсюду: Микробы находятся не только на наших руках, но и везде вокруг нас — на предметах, которые мы трогаем, на поверхности столов, а также в воздухе. На одном квадратном сантиметре кожи может находиться до 1 миллиона микробов!
-
Разнообразие форм: Микробы могут иметь самые разные формы — от круглых (кокки) до палочковидных (бациллы) и спиралевидных (спириллы). Под микроскопом они выглядят как маленькие “животные” с различными цветами и текстурами, что делает их изучение очень увлекательным.
-
Полезные и вредные микробы: Не все микробы вредны! Некоторые из них помогают нам переваривать пищу и защищают от болезней. Например, в нашем кишечнике живут полезные бактерии, которые помогают усваивать витамины и минералы.
Эти факты помогут детям понять, насколько разнообразен и интересен мир микробов!

Стрептококки и стафилококки
В следующем разделе представлено описание самых распространенных бактерий, которые обитают в ротовой полости и на коже человека.
Микробы — это мельчайшие организмы, которые можно рассмотреть только с помощью микроскопа. Они находятся повсюду: на руках, в ротовой полости, под ногтями и даже в воздухе. Большинство из них безопасны, однако некоторые способны вызывать заболевания. На микроскопических снимках микробы выглядят как яркие и необычные формы: шарики, палочки и спирали. Например, стафилококки напоминают гроздья винограда, а кишечная палочка имеет форму палочки.
Для детей важно осознавать, что микробы могут быть как полезными, так и опасными. Полезные микробы способствуют перевариванию пищи и защищают организм от болезней. Чтобы показать разнообразие микробов, можно подготовить презентацию с яркими изображениями и увлекательными фактами. Это поможет детям лучше понять, как микробы влияют на нашу жизнь и почему соблюдение гигиенических норм так важно.
Стрептококки в ротовой полости
Самые первые из бактерий, которые попадают в ротовую полость младенца во время движения ребенка по родовым путям. На сегодня учеными выделены 17 видов стрептококков, содержащих С-антиген, и стрептококки, лишенные этого антигена. Именно микробы без такого антигена и вызывают кариес. Такие стрептококки есть в слюне и в карманах десен у всех без исключения людей.
Стрептококки могут стремительно разрастаться: для этого нужна температура в 37 градусов и глюкоза с углеводами. Поэтому во время ангин давать сладости больным детям не рекомендуется.
Стрептококки на коже
Микроорганизмы могут попасть на кожу человека различными способами:
- Через вдыхаемый воздух или пыль.
- При контакте с зараженными предметами, такими как детские игрушки, поручни общественного транспорта, деньги, книги и одежда других людей.
- В результате рукопожатий или других прикосновений.
- Во время медицинских процедур, проводимых с использованием нестерильных инструментов.
- С почвы или немытых фруктов, а также при употреблении пищи грязными руками.
Инфекции легче проникают в организм, если он ослаблен. Это может происходить в следующих случаях:
- У детей, у которых защитные механизмы еще не полностью развиты, или у тех, чей иммунитет ослаблен по внешним причинам.
- При значительных изменениях кислотно-щелочного баланса кожи, который в норме составляет 5,2 — 5,5 единиц.
- В случае гормональных нарушений, так как именно гормоны регулируют обменные процессы и жизнедеятельность клеток.
- Если кожа повреждена: наличием ран, ссадин, солнечных ожогов или укусами насекомых.
Стрептококк может вызывать два серьезных заболевания: рожистое воспаление и стрептодермию. Оба эти состояния могут привести к заражению крови и даже к летальному исходу. Стрептодермия делится на три типа: поверхностный, язвенный и глубокий.
Стаффилококки во рту
Эти продолговатые бактерии – вторые по численности жители полости рта. На фото микроскопа их скопления напоминают гроздь винограда. Излюбленное место скопления таких бактерий – зона у основания десен и налет на зубах. Размножаться такие микроорганизмы способны при температурах от 7 до 46 градусов. Но наиболее подходят для них 35-39 градусов тепла.
В условиях простой среды популяция стафилококков очень быстро разрастается. Расщепляя углеводы, они вырабатывают кислоту. Перерабатывают стафилококки и белки. Результатом такой переработки становится сероводород. Стафилококки ведут к быстрому развитию зубного налета.
Стаффилококки на коже
Эти бактерии обитают на поверхности кожи и слизистых оболочках живых организмов, а также на продуктах питания и предметах домашнего обихода. Заболевания они вызывают только в том случае, если иммунная система человека ослаблена и не может эффективно бороться с микробами. Основные пути передачи стафилококка включают воздушно-капельный путь и прямой контакт с кожей инфицированного человека или предметами, на которых находятся эти микроорганизмы.
Когда стафилококк попадает на кожу, это всегда сопровождается болезненными ощущениями. В области заражения наблюдаются отек, гнойные образования, болевые ощущения и покраснение кожи. Основным признаком является разнообразная сыпь на поверхности кожи.
Сыпь может проявляться в следующих формах:
- абсцессы;
- крупные красные пятна;
- пузырьки с жидкостью внутри;
- воспаления в области ногтей;
- прыщи;
На лице золотистый стафилококк часто вызывает множество угрей. В таких случаях воспаления кожи выглядят как ярко-красные болезненные бугорки. Вскоре в центре угря образуется белый гной, который затем может прорваться, оставляя после себя небольшую ямку или шрам. На руках стафилококки чаще всего поражают ногтевые фаланги.
Симптомы заболевания включают:
- гнойные образования в месте инфицирования;
- отек и опухание кожи;
- интенсивная пульсирующая боль;
- изменение цвета кожи и ногтевой пластины.
Стафилококк может появляться на любой части тела, однако чаще всего страдают спина, грудь и живот. В основном это те же угри с гнойным содержимым, но также могут возникать и более серьезные формы, такие как фурункулы.
В народе их называют чирьями. В центре фурункула находится длинный гнойный стержень, который проникает в глубокие слои кожи. Фурункулы чаще всего образуются в местах расположения сальных, потовых или волосяных желез. Еще одной формой заболевания, вызванного стафилококками, является рожистое воспаление кожи.
Признаки рожистого воспаления:
- в области воспаления наблюдается отек и повышение температуры тела;
- на коже появляется крупное красное пятно;
- иногда формируются прозрачные пузырьки, заполненные гнойным содержимым;
- возникают множественные мелкие точечные кровоизлияния.
Грибки на коже
На теле грибковые инфекции могут развиваться в любом месте: на голове, стопах, ягодицах или на ладонях.
Самыми распространенными формами являются такие:
- Дерматофития: поражение глубоких слоев кожи, которое вызывается и дрожжевыми, и плесневыми грибами. Самое частое заболевание из серии грибковых. Такое заражение запускает воспалительный процесс и приводит к образованию пятен или бляшек розового или красного цвета. Размер таких бляшек – самый разнообразный. Грибы, вызывающие дерматофитию — постоянные жители волос и кожи. Они способны отлично поглощать и усваивать кератин волос и ногтей.
- Кератомикоз: заболевание, поражающее верхний слой кожи. Симптомы болезни – твердые небольшие узелки на коже, которые наполнены гноем. Формы заболевания различны и включают в себя отрубевидный лишай, подмышечный трихомикоз и эритразму.
- Глубокий микоз: болезнь настигает подкожную клетчатку, мышцы, суставы и кости, слизистую оболочку, ткани внутренних органов и части нервной системы. На коже при таком поражении появляются бородавки и глубокие свищи.
- Кандидоз: инфекцию вызывают дрожжевые грибки. Места самого частого поражения на теле находятся в паховой области, в подмышечных впадинах и под женской грудью.
От места поражения и вида грибка зависит проявление болезни.
Кандиды и дерматофиты вызывают зуд, изменение цвета кожи на красно-синюшный, шелушение зараженных областей, перхоть и сухость волос, изменение цвета ногтей.
При микозе стопы, помимо шелушения кожи, возникают пузырьки до 2 мм в диаметре, заполненные жидкостью. Собираются такие пузырьки между пальцами ног. Неприятности больному доставляет и запах, появляющийся при распаде грибка. Часто такие заболевания человек получает в сауне или летом, при многочасовом ношении тесной обуви.
Попадая на кожу лица, грибки сначала поражают мертвые клетки эпителия. Если лечения не проводить, то начинается шелушение кожи, огрубение, появление красных или желтых пятен. При переходе в тяжелую стадию появляются гнойные очаги и язвы. Начинаются грибковые поражения внутренних органов.
На голове грибковые поражения приводят к выпадению волос, шелушение, перхоть, образование залысин.
Микробы на руках: как они выглядят под микроскопом
Фото микробов, сделанное под микроскопом, рекомендуется показывать детям, которые забывают о важности мытья рук. Это изображение ладошки восьмилетнего сына калифорнийского микробиолога Таши Штурм, работающей в колледже Кабрильо.
На снимке, где микробы представлены в большом количестве, видно, что даже у здорового ребенка есть микробы. Мальчик, чья ладонь запечатлена на фото, всего лишь немного поиграл в доме и с собакой.
Изображение детской ладони, покрытой микробами:
Расшифровка изображения выглядит следующим образом:
- белые колонии микробов у кончиков пальцев – стафилококки;
- желтым цветом выделены микрококки;
- колонии, окрашенные в розовый цвет – серратия.
Стафилококки и микрококки обычно безопасны и являются частью естественной микрофлоры человека. В то же время серратия может вызывать инфекции, особенно у людей с ослабленным иммунитетом.
На руках, помимо уже упомянутых стрептококков, стафилококков и грибковых бактерий, можно обнаружить следующие микробы:
- сальмонеллы, представляющие собой палочки длиной до 7 мкм, которые могут вызывать кишечные инфекции, включая тяжелый брюшной тиф;
- кишечную палочку размером 0,4—0,8 × 1—3 мкм, способную привести к серьезным отравлениям, особенно у пожилых людей и маленьких детей;
- шигеллы, вызывающие дизентерию и судороги у детей;
- шарикоподобные бруцеллы, не имеющие жгутиков, которые могут поражать внутренние органы.
Микробы, которые живут под ногтями
В зоне под ногтями встречаются все виды бактерий, живущих на руках. Но концентрация таких микробов в сотни раз выше. Это связано с труднодоступностью пространства под ногтями для обработки дезинфицирующими и противовоспалительными средствами.
Интересно, что под искусственными накладными ногтями таких микробов в разы больше, чем под натуральными.
Постоянные жители организма, населяющие эту зону:
- грибковые бактерии;
- стафилококки,
- стрептококки.
Сложность дезинфекции пальцев в том, что ногтевая пластинка надежно защищает эту часть тела от действия самых эффективных антибактериальных средств.
Бактерии, живущие в кишечнике
Ученые утверждают, что в человеческом кишечнике обитает более 2000 различных видов бактерий. Среди них находятся как полезные микроорганизмы, так и патогенные микробы, способные вызывать заболевания. Точное количество бактерий подсчитать сложно, но по оценкам науки, их число может достигать до 100 триллионов. Если перевести это в вес, то от 200 граммов до 1 килограмма массы нашего тела составляют кишечные бактерии.
Тонкий кишечник, в отличие от толстого, содержит меньшее разнообразие бактерий. Это связано с тем, что в тонком кишечнике более кислая среда, больше кислорода и антимикробных веществ. Поэтому здесь развиваются быстрорастущие микроорганизмы, которые способны активно прикрепляться к стенкам. Бактерии толстого кишечника, в свою очередь, получают питательные вещества из углеводов, которые не были расщеплены в тонком кишечнике.
Ключевые функции полезных бактерий кишечника:
- Синтезируют витамины группы В и К;
- Оказывают прямое влияние на функционирование мозга, внутренних органов и психическое состояние;
- Способствуют более эффективному извлечению энергии из пищи;
- Укрепляют кишечный барьер;
- Помогают в производстве желчных кислот;
- Разлагают токсичные вещества и канцерогенные клетки.
Основная часть кишечных бактерий относится к двум группам: фирмикуты и бактероиды.
Кроме этих двух групп, составляющих до 90% всей микрофлоры кишечника, в нем обитают и другие популяции:
- Актинобактерии, имеющие форму ветвящихся нитей.
- Бифидобактерии, напоминающие изогнутые палочки длиной до 5 мкм, которые борются с вредными гнилостными микроорганизмами.
- Лактобациллы, вырабатывающие молочную кислоту из лактозы и углеводов. Кислая среда, образующаяся в результате их деятельности, препятствует росту патогенных бактерий.
- Протеобактерии, представляющие собой разнообразную группу, включающую почти треть всех известных бактерий. Они различаются по форме, способам дыхания и передвижения. Среди них есть как полезные для человека, так и те, что могут вызывать инфекции.
Микрофлора кишечника у детей меняется в зависимости от возраста. У детей на искусственном вскармливании наблюдается равное соотношение бактероидов и бифидобактерий, а также присутствуют стафилококки и клостридии. Кишечная палочка также обязательна в этом случае.
У детей, питающихся материнским молоком, микрофлора состоит из лактобацилл и стрептококков. Микробы, наблюдаемые под микроскопом (например, кишечные палочки, вызывающие бактериальную диарею), показывают, насколько они многочисленны.
Презентации для детей включают фотографии микробов, которые можно увидеть на руках и слизистых оболочках под микроскопом. Они помогают детям понять важность мытья рук, купания, чистки зубов, употребления мытых фруктов и избегания контакта с бродячими животными. Эти изображения сопровождаются текстовыми пояснениями и звуковыми эффектами.
Видео о микробах
Микробы в капле грязной воды под микроскопом:
Как защитить себя от вредных микробов
Защита от вредных микробов — это важный аспект поддержания здоровья и профилактики заболеваний. Существует множество способов, которые помогут минимизировать риск заражения и распространения микробов. Рассмотрим основные из них.
1. Регулярное мытье рук. Один из самых эффективных способов борьбы с микробами — это частое и правильное мытье рук. Используйте мыло и теплую воду, тщательно мойте руки не менее 20 секунд, особенно после посещения общественных мест, перед едой и после использования туалета. Если мыла нет под рукой, можно использовать антисептики на спиртовой основе.
2. Соблюдение личной гигиены. Личная гигиена включает в себя не только мытье рук, но и регулярное принятие душа, чистку зубов, а также уход за ногтями. Длинные ногти могут накапливать микробы, поэтому их следует подстригать и чистить. Также важно следить за состоянием кожи, так как повреждения могут стать входными воротами для инфекций.
3. Избегание контакта с больными. Если вы знаете, что кто-то из вашего окружения болен, старайтесь избегать близкого контакта с ним. Микробы могут передаваться через воздух, капли слюны и даже через предметы, которые использует больной человек.
4. Дезинфекция поверхностей. Микробы могут долго сохраняться на различных поверхностях, таких как дверные ручки, столы, телефоны и другие предметы обихода. Регулярная дезинфекция этих поверхностей поможет снизить риск заражения. Используйте специальные дезинфицирующие средства, особенно в общественных местах и в доме, если кто-то из членов семьи болен.
5. Правильное питание и укрепление иммунитета. Здоровое питание, богатое витаминами и минералами, помогает укрепить иммунную систему, что делает организм менее восприимчивым к инфекциям. Употребляйте больше фруктов, овощей, орехов и цельнозерновых продуктов. Также важно пить достаточное количество воды и избегать избыточного потребления сахара и обработанных продуктов.
6. Вакцинация. Вакцинация — это один из самых эффективных способов защиты от многих инфекционных заболеваний. Убедитесь, что вы и ваши дети получили все необходимые прививки в соответствии с графиком вакцинации.
7. Обучение детей. Важно объяснять детям, как правильно заботиться о своей гигиене. Научите их мыть руки, не трогать лицо грязными руками и избегать обмена личными вещами с другими детьми.
Следуя этим простым рекомендациям, вы сможете значительно снизить риск заражения вредными микробами и сохранить здоровье своей семьи.
Вопрос-ответ
Как можно увидеть микробы на руках под микроскопом?
Увидеть бактерии в микроскоп можно при увеличении от 160 крат и выше. Для работы с микроорганизмами вам будет достаточно биологического микроскопа с увеличением до 400 крат. Но если есть возможность — приобретите микроскоп с максимальным увеличением 800 крат или выше.
Кто такие микробы для детей?
Проще говоря, микробы — это крошечные живые организмы, которые могут проникать в наши тела и заставлять нас болеть, когда мы не выполняем надлежащую гигиену.
Как можно увидеть микробы под микроскопом?
В микроскоп, способный давать увеличение не менее 600-800х крат, можно понаблюдать не только простейших, но и бактерий. Самый простой способ это сделать – собрать небольшое количество зубного налета и развести его в капельке воды. Так можно увидеть основных представителей царства бактерий.
Что такое микробы?
Микрооргани́змы, или микро́бы (фр. Microbe, от греч. μικρό — маленький и βίος — жизнь) — собирательное название живых организмов, которые слишком малы для того, чтобы быть видимыми невооружённым глазом.
Советы
СОВЕТ №1
Используйте яркие и понятные иллюстрации. При подготовке презентации для детей важно включить красочные фотографии микробов, чтобы визуально заинтересовать их и облегчить понимание темы.
СОВЕТ №2
Объясняйте простыми словами. Избегайте сложной терминологии и научных jargon. Используйте доступные и понятные примеры из повседневной жизни, чтобы дети могли легко усвоить информацию о микробах.
СОВЕТ №3
Включите интерактивные элементы. Задавайте детям вопросы, проводите небольшие эксперименты или игры, связанные с микробами, чтобы сделать обучение более увлекательным и запоминающимся.
СОВЕТ №4
Обсудите важность гигиены. Включите в презентацию информацию о том, как микробы могут влиять на здоровье, и расскажите о простых мерах гигиены, таких как мытье рук, чтобы дети понимали, как защитить себя от вредных микробов.